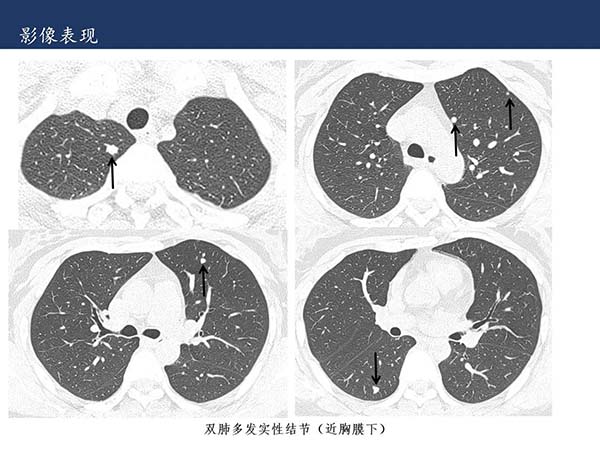
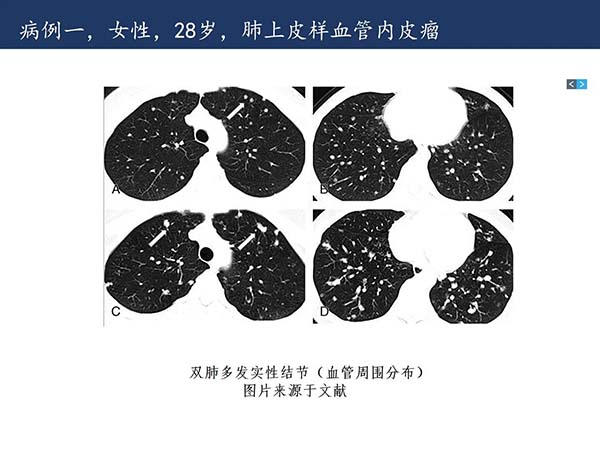

科普文章
【杨柳科普】肺上皮样血管内皮瘤的影像表现

























本文仅限于学术交流,如有不适请及时就医。
- 标签:

本文仅限于学术交流,如有不适请及时就医。
地址:北京市朝阳区垂杨柳南街2号 邮编:100022
医院总机:67700622
本站内容仅供参考,不作为诊断及医疗依据
京ICP备2021013991号
京公网安备11010502033717号
版权所有:北京市垂杨柳医院
技术支持:54Doctor
京ICP备2021013991号
京公网安备11010502033717号
版权所有:北京市垂杨柳医院 技术支持:54Doctor

